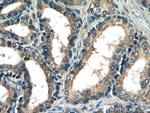
HTR4 Antibody in Immunohistochemistry (Paraffin) (IHC (P))

Search
Proteintech
HTR4 Polyclonal Antibody
{{$productOrderCtrl.translations['antibody.pdp.commerceCard.promotion.promotions']}}
{{$productOrderCtrl.translations['antibody.pdp.commerceCard.promotion.viewpromo']}}
{{$productOrderCtrl.translations['antibody.pdp.commerceCard.promotion.promocode']}}: {{promo.promoCode}} {{promo.promoTitle}} {{promo.promoDescription}}. {{$productOrderCtrl.translations['antibody.pdp.commerceCard.promotion.learnmore']}}
产品信息
21165-1-AP
种属反应
已发表种属
宿主/亚型
分类
类型
抗原
偶联物
形式
浓度
规格
纯化类型
保存液
内含物
保存条件
运输条件
产品详细信息
Immunogen sequence: GYINSGLNP FLYAFLNKSF RRAFLIILCC DDERYRRPSI LGQTVPCSTT TINGSTHVLR DAVECGGQWE SQCHPPATSP LVAAQPSDT (301-388 aa encoded by BC074755)
靶标信息
This gene is a member of the family of serotonin receptors, which are G protein coupled receptors that stimulate cAMP production in response to serotonin (5-hydroxytryptamine). The gene product is a glycosylated transmembrane protein that functions in both the peripheral and central nervous system to modulate the release of various neurotransmitters. Multiple transcript variants encoding proteins with distinct C-terminal sequences have been described, but the full-length nature of some transcript variants has not been determined.
仅用于科研。不用于诊断过程。未经明确授权不得转售。
生物信息学
蛋白别名: 5-HT-4; 5-HT4 receptor; 5-HT4b; G protein-coupled; 5-hydroxytryptamine (serotonin) receptor 4, G protein-coupled; 5-hydroxytryptamine receptor 4; 5HT4; 5HT4 receptor; cardiac 5-HT4 receptor; Serotonin receptor 4
基因别名: 5-HT-4; 5-HT4; 5-HT4R; 5-HT<4L>; 5HTR4; HTR4
UniProt ID: (Human) Q13639, (Mouse) P97288
Entrez Gene ID: (Human) 3360, (Mouse) 15562